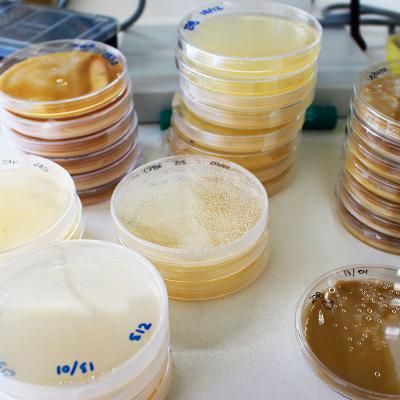

O INIAV possui grande diversidade de colecções biológicas, desde insectos, agentes zoonóticos e de bioterrorismo, agentes patogénicos para os animais e para as plantas (fungos e bactérias), até microrganismos relevantes em processos industriais e alimentares e de interesse agronómico, florestal e ambiental.
As seis colecções, que constituem os Recursos Genéticos Microbianos do INIAV estão agrupadas na designada Agronomic, Veterinary and Food Microbial Culture Collections (AVFMCC).
Esta colecção faz parte da Pt.mBRCN/MIRRI-PT – Rede Portuguesa de Centros de Recursos Microbiológicos do MIRRI (pan-European Microbial Resource Research Infrastructure) que inclui sete países Europeus.
Em Março de 2020 a Pt.mBRCN/MIRRI-PT foi incluída no Roteiro Nacional de Infraestruturas de Investigação de Interesse Estratégico (RNIE), FCT - pag.60.
As seis colecções que
constituem a AVFMCC
MEAN - Micoteca da ex-Estação Agronómica Nacional
LNRSA - Bacterioteca do Laboratório Nacional de Referência da Saúde Animal
O LNRSA - bacterioteca do Laboratório Nacional de Referência da Saúde Animal, possui cerca de 10 000 estirpes bacterianas, associadas a casos clínicos, zoonoses e surtos de doenças infecciosas animais:
- 500 estirpes, isoladas entre 1952 e 1990, utilizadas para produção de vacinas de rebanho;
- 5398 estirpes de Enterobacteriaceae, Staphylococcus e Streptococcus caracterizadas em relação ao perfil de resistência a antibióticos;
- 2813 estirpes de Brucella;
- 186 estirpes de Mycoplasma mycoides subsp mycoides;
- 153 estirpes de Mycoplasma bovis e de Mycoplasma agalactiae;
- 885 estirpes do Complexo Mycobacterium tuberculosis.
 |
 |
CNFB - Colecção de Bactérias Fixadoras do Azoto (Nitrogen Fixation Bacteria)
A CNFB - Colecção de Bactérias Fixadoras do Azoto (Nitrogen Fixation Bacteria) é constituída por vários géneros de bactérias do grupo Rhizobium, isoladas de diferentes leguminosas:
- 200 estirpes de Rhizobium leguminosarum bv. trifolii;
- 205 estirpes de Sinorhizobium spp;
- 40 estirpes de Mesorhizobium loti;
- 75 estirpes de Bradyrhizobium spp;






(I) não inoculadas;
(II) inoculado com Rhizobium


EVN – Colecção da ex-Estação Vitivinícola Nacional
A EVN – Colecção da ex-Estação Vitivinícola Nacional é constituída por:
- 21 estirpes de bactérias
- 1196 estirpes de leveduras e
- 12 estirpes de fungos filamentosos, isolados de ambientes vínicos

CPBF – Coleção Portuguesa de Bactérias Fitopatogénicas
A Coleção Portuguesa de Bactérias Fitopatogénicas (CPBF) é uma coleção de trabalho criada na década de 90 e composta por mais de 1500 exemplares, tendo como coletores investigadores portugueses ou depositados por intercambio com fitobacteriologistas internacionais.
Conta com uma panóplia de estirpes bacterianas crioconservadas constituída por isolados de organismos de quarentena e de qualidade associados a plantas agrícolas, florestais, ornamentais e espontâneas, bem como de origem ambiental.
LMAI – Colecção do Laboratório de Microbiologia dos Alimentos e do Laboratório de Microbiologia Industrial do ex-INETI
A LMAI – Colecção do Laboratório de Microbiologia dos Alimentos e do Laboratório de Microbiologia Industrial do ex-INETI é constítuida por:
- 3050 bactérias, leveduras e fungos filamentosos.